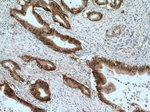
AHNAK2 Antibody in Immunohistochemistry (Paraffin) (IHC (P))

Search
Proteintech
AHNAK2 Polyclonal Antibody
{{$productOrderCtrl.translations['antibody.pdp.commerceCard.promotion.promotions']}}
{{$productOrderCtrl.translations['antibody.pdp.commerceCard.promotion.viewpromo']}}
{{$productOrderCtrl.translations['antibody.pdp.commerceCard.promotion.promocode']}}: {{promo.promoCode}} {{promo.promoTitle}} {{promo.promoDescription}}. {{$productOrderCtrl.translations['antibody.pdp.commerceCard.promotion.learnmore']}}
产品信息
17682-1-AP
种属反应
已发表种属
宿主/亚型
分类
类型
抗原
偶联物
形式
浓度
规格
纯化类型
保存液
内含物
保存条件
运输条件
产品详细信息
Immunogen sequence: EQPVDLNLP LEAPPISKVR VHIQGAQVES QEVTIHSIVT PEFVDLSVPR TFSTQIVRES EIPTSEIQTP SYGFSLLKVK IPEPHTQARV YTTMTQHSRT QEGTEEAPIQ ATPGVDSISG DLQPDTGEPF EMISSSVNVL GQQTLTFEVP SGHQLADSCS DEEPAEILEF PPDDSQEATT PLADEGRAPK DKPESKKSGL LWFWLPNIGF SSSVDETGVD SKNDVQRSAP IQTQPEARPE AELPKKQEKA GWFRFPKLGF SSSPTKKSKS TEDGAELEEQ KLQEETITFF DARESFSPEE KEEGELIGPV GTGLDSRVMV TSAARTELIL PEQDRKADDE SKGSGLGPNE G (134-483 aa encoded by BC049216)
靶标信息
The specific function of AHNAK2 is not yet known.
仅用于科研。不用于诊断过程。未经明确授权不得转售。
生物信息学
蛋白别名: Protein AHNAK2
基因别名: AHNAK2; C14orf78; KIAA2019
UniProt ID: (Human) Q8IVF2
Entrez Gene ID: (Human) 113146